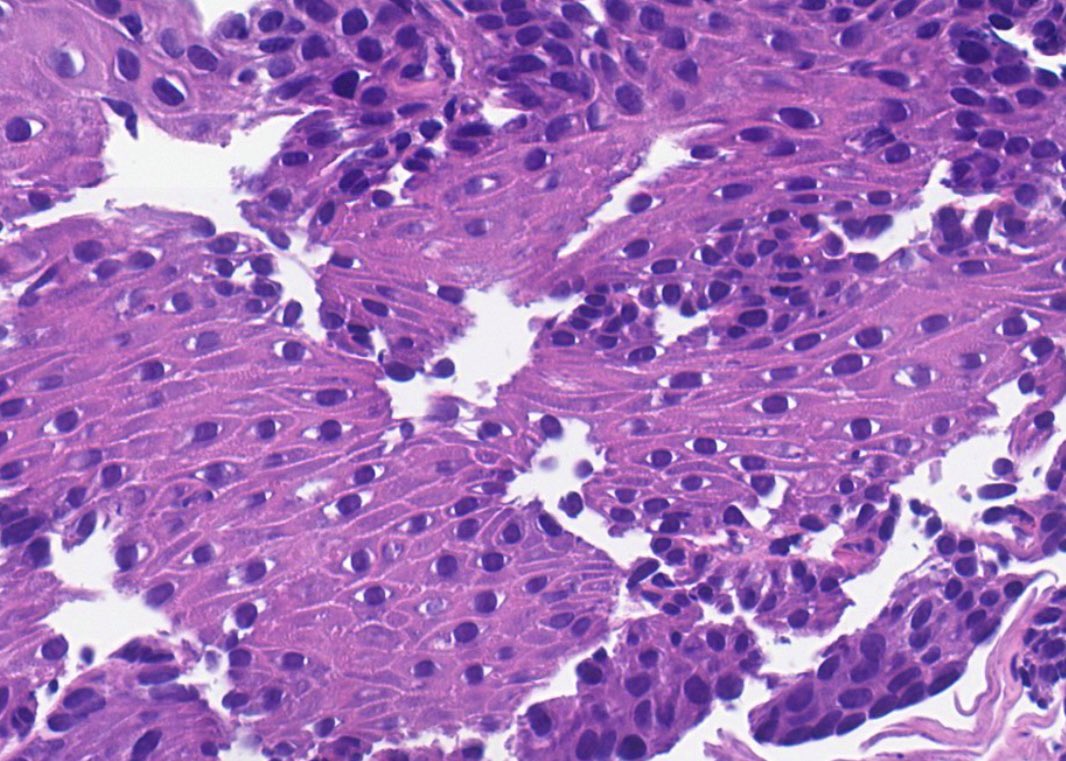

Cacey Peters, MD, FCAP, FASDP
@caceypeters
(#Music + #Physics) ➡️ MD ➡️ #Pathology (AP/CP) ➡️ #Dermpath
(#dermtwitter #dermatology #Histology #MedEd #medtwitter #pathplanet #pathart #histologyinmotion)
ID: 189005386
http://pathologywatch.com 10-09-2010 03:30:44
801 Tweet
1,1K Takipçi
253 Takip Edilen













Tune in as Dermpath Dr. Cacey Peters sheds some knowledge on Herpes in our latest 'Getting Under Your Skin' episode. Cacey Peters, MD, FCAP, FASDP #Dermpathdrpeters #gettingunderyourskin #letstakeacloserlook #pathologywatch





#ThrowbackThursday In 2014, Dr. Brian Hoyt and Dr. Jag Bhawan wrote this CME article on histological spectrum of cutaneous herpes infections and how herpes can masquerade as a variety of hematologic malignancies or benign cutaneous conditions. Boston University


#WhatsNewInDermpath Klaus Busam Melissa Pulitzer, MD Konstantinos LinosMD Memorial Sloan Kettering Cancer Center Dartmouth Health Pathology Residency Geisel School of Medicine at Dartmouth present a cohort of 11 cases of Wnt-activated deep penetrating/plexiform melanocytomas/nevi (DPN) with a junctional component